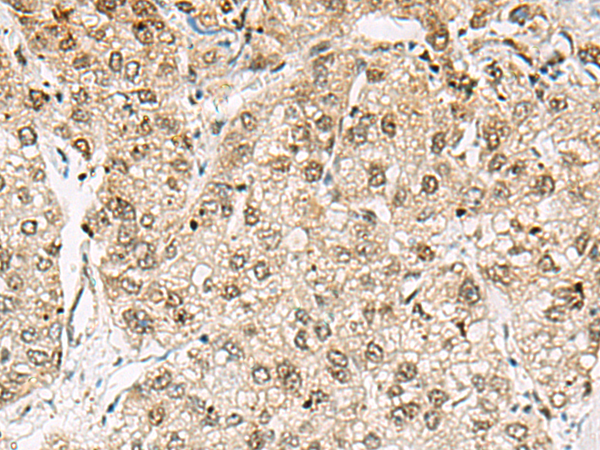

中文名稱:兔抗CBX8多克隆抗體
英文名稱: Anti-CBX8 rabbit polyclonal antibody
別 名: PC3, RC1
儲 存: 冷凍(-20℃)
反應(yīng)種屬: Human
標(biāo) 記 物: Unconjugate
克隆類型: rabbit polyclonal
技術(shù)規(guī)格
|
Background: |
Component of a Polycomb group (PcG) multiprotein PRC1-like complex, a complex class required to maintain the transcriptionally repressive state of many genes, including Hox genes, throughout development. PcG PRC1 complex acts via chromatin remodeling and modification of histones; it mediates monoubiquitination of histone H2A 'Lys-119', rendering chromatin heritably changed in its expressibility. |
|
Applications: |
ELISA, WB, IHC |
|
Name of antibody: |
CBX8 |
|
Immunogen: |
Fusion protein of human CBX8 |
|
Full name: |
chromobox 8 |
|
Synonyms: |
PC3; RC1 |
|
SwissProt: |
Q9HC52 |
|
ELISA Recommended dilution: |
5000-10000 |
|
IHC positive control: |
Human liver cancer |
|
IHC Recommend dilution: |
50-100 |
|
WB Predicted band size: |
43 kDa |
|
WB Positive control: |
231 and 293T cell lysates |
|
WB Recommended dilution: |
500-2000 |

購物車
購物車 幫助
幫助
 021-54845833/15800441009
021-54845833/15800441009
